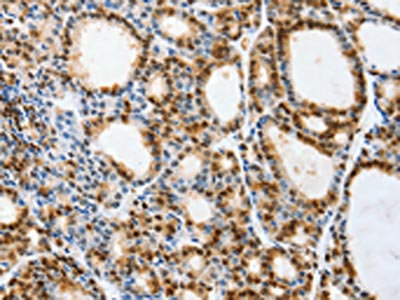

VIMP Antibody
-
中文名稱:VIMP兔多克隆抗體
-
貨號(hào):CSB-PA233851
-
規(guī)格:¥1100
-
圖片:
-
其他:
產(chǎn)品詳情
-
Uniprot No.:
-
基因名:
-
別名:SELENOS antibody; SELS antibody; VIMP antibody; AD-015 antibody; SBBI8 antibody; Selenoprotein S antibody; SelS antibody; VCP-interacting membrane protein antibody
-
宿主:Rabbit
-
反應(yīng)種屬:Human,Mouse,Rat
-
免疫原:Synthetic peptide of Human VIMP
-
免疫原種屬:Homo sapiens (Human)
-
標(biāo)記方式:Non-conjugated
-
抗體亞型:IgG
-
純化方式:Antigen affinity purification
-
濃度:It differs from different batches. Please contact us to confirm it.
-
保存緩沖液:-20°C, pH7.4 PBS, 0.05% NaN3, 40% Glycerol
-
產(chǎn)品提供形式:Liquid
-
應(yīng)用范圍:ELISA,IHC
-
推薦稀釋比:
Application Recommended Dilution ELISA 1:2000-1:5000 IHC 1:50-1:200 -
Protocols:
-
儲(chǔ)存條件:Upon receipt, store at -20°C or -80°C. Avoid repeated freeze.
-
貨期:Basically, we can dispatch the products out in 1-3 working days after receiving your orders. Delivery time maybe differs from different purchasing way or location, please kindly consult your local distributors for specific delivery time.
-
用途:For Research Use Only. Not for use in diagnostic or therapeutic procedures.
相關(guān)產(chǎn)品
靶點(diǎn)詳情
-
功能:Involved in the degradation process of misfolded endoplasmic reticulum (ER) luminal proteins. Participates in the transfer of misfolded proteins from the ER to the cytosol, where they are destroyed by the proteasome in a ubiquitin-dependent manner. Probably acts by serving as a linker between DERL1, which mediates the retrotranslocation of misfolded proteins into the cytosol, and the ATPase complex VCP, which mediates the translocation and ubiquitination.
-
基因功能參考文獻(xiàn):
- In these studies found that SelS increases in negative correlation with tau phosphorylation in brain. PMID: 27802219
- The results suggest that SelS is required for C99 degradation through endoplasmic reticulum-associated degradation, resulting in inhibition of amyloid beta production. PMID: 28315680
- regulating liver and serum Selenoprotein S levels might become a new strategy for the prevention and treatment of DM and its macrovascular complications PMID: 27121097
- SEPS1 may be a potential gene marker for disease diagnosis and prognosis. PMID: 26382012
- interaction between SelK and p97(VCP) is SelS-dependent, and the resulting ERAD complex (SelS-p97(VCP)-SelK) plays an important role in ERAD and ER stress PMID: 26504085
- Potential roles of the SEPS1 gene in the pathogenesis and etiology of Hashimoto's thyroiditis. PMID: 26016409
- SNP rs4965814 of SELS may affect the susceptibility to ischemic stroke. PMID: 25390504
- The SEPS1 -105G>A is associated with an increased risk of Kashin-Beck disease and influences the expression of PI3K/Akt signaling pathway in Kashin-Beck disease patients PMID: 25433273
- Although VIMP can interact with CLIMP-63 and Syn5L, it does not interact with MT-binding ER proteins (such as Reep1) that shape the tubular smooth ER PMID: 25008318
- Selenoprotein S is a marker but not a regulator of endoplasmic reticulum stress in intestinal epithelial cells in inflammatory bowel diseases. PMID: 24275540
- Pro(178) and Pro(183) of SelS play important roles in the translocation of p97(VCP) to the ER membrane and protect cells from ER stress PMID: 24700463
- that SEPS1 may protect mice against LPS-induced sepsis and organ damage. Therefore, SEPS1 may be a new target to resolve LPS-induced sepsis. PMID: 24573439
- Existence of a link between SEPS1 promoter genetic variation and Hashimoto thyroiditis risk. PMID: 24471570
- Findings suggest that the SEPS1 G-105A polymorphism contributes to the risk of developing SPTB in a Chinese population. PMID: 23776519
- Our results indicated that the rs12910524 in the Tanis gene was associated with triglyceride concentrations in subjects without diabetes in China. PMID: 23829426
- Data suggest that selenocysteine allows selenoprotein S (SelS, VIMP) to sustain activity under oxidative stress. PMID: 23914919
- These results suggest a potential role for the SELS region in the development subclinical cardiovascular disease in this sample enriched for type 2 diabetes mellitus. PMID: 23161441
- the redox properties observed for recombinant VIMP are compatible with a function as a reductase PMID: 22700979
- Upregulation of SelS expression in reactive astrocytes reveals a new protective role for SelS against inflammation and endoplasmic reticulum stress that can be relevant to astrocyte function. PMID: 21456042
- a role for SELS in the development of metabolic disease, especially in the context of insulin resistance. PMID: 20619427
- beta-ME, also an ER stress agent, could induce cell apoptosis, and SelS may play an important role in protecting cells from apoptosis induced by ER stress in HepG2 cells. PMID: 20114070
- SELS is regulated by glucose deprivation and endoplasmic reticulum stress. It is a glucose-regulated protein. PMID: 15063746
- Positive relationship between Tanis mRNA and the acute-phase protein serum amyloid A suggests an interaction between innate immune system responses and Tanis expression in muscle and adipose tissue. PMID: 15161744
- Derlin-1 interacts with US11, a virally encoded ER protein that specifically targets MHC class I heavy chains for export from the ER, as well as with VIMP, a novel membrane protein that recruits the p97 ATPase and its cofactor PMID: 15215856
- SEPS1 may regulate cytokine production in macrophage cells and there may be a regulatory loop between TNF-alpha, IL-1beta and SEPS1 that plays a key role in control of the inflammatory response PMID: 16574427
- SEPS1 protein is secreted from hepatoma cells. Fractionation of human serum indicated that SEPS1 was associated with LDL and possibly with VLDL. PMID: 17374524
- significant association with increased CHD risk in females carrying the minor allele of rs8025174. Another variant, rs7178239, increased the risk for ischemic stroke significantly in females. PMID: 17641917
- -105G>A polymorphism is not associated with IBD susceptibility and does not contribute to a certain disease phenotype or increased TNF-alpha levels in IBD patients. PMID: 17661913
- Selenoprotein S -105(adenosine) allele is a non-significant risk factor in young stroke patients from Italy and Germany. PMID: 17880573
- Six polymorphisms were studied in this gene, and none are associated with type 1 diabetes, rheumatoid arthritis or inflammatory bowel diseases. PMID: 18625033
- SelS has a role in lipopolysaccharide-induced inflammatory response in hepatoma HepG2 cells PMID: 18675776
- SelS protein may be involved in insulin resistance in Chinese with type 2 diabetes mellitus (T2DM) by acting as the SAA receptor, thus playing an important role in the development of T2DM and atherosclerosis PMID: 18710632
- The -105G>A promoter polymorphism of SEPS1 was associated with the intestinal type of gastric cancer. PMID: 19144102
- Selenoprotein S/SEPS1 modifies endoplasmic reticulum stress in Z variant alpha1-antitrypsin deficiency. PMID: 19398551
- Regulatory variant in SELS influences inflammatory response to ER stress PMID: 16227999
顯示更多
收起更多
-
亞細(xì)胞定位:Endoplasmic reticulum membrane; Single-pass membrane protein. Cytoplasm.
-
蛋白家族:Selenoprotein S family
-
數(shù)據(jù)庫鏈接:
Most popular with customers
-
-
YWHAB Recombinant Monoclonal Antibody
Applications: ELISA, WB, IHC, IF, FC
Species Reactivity: Human, Mouse, Rat
-
Phospho-YAP1 (S127) Recombinant Monoclonal Antibody
Applications: ELISA, WB, IHC
Species Reactivity: Human
-
-
-
-
-